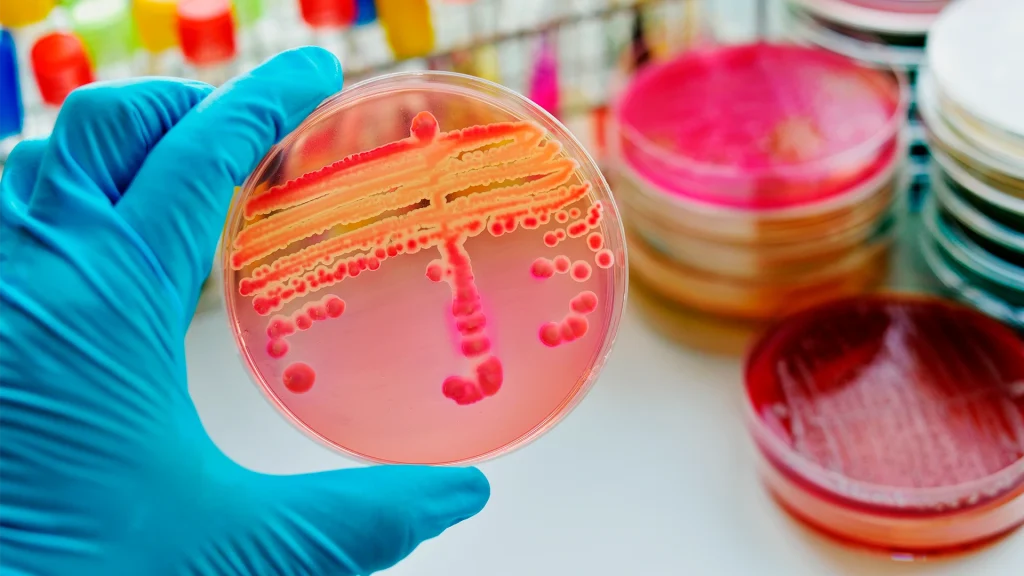

A agricultura moderna exige cada vez mais eficiência e sustentabilidade. No controle de pragas sugadoras, como a cigarrinha-do-milho, os percevejos, mosca-branca e o pisílideo no citrus, o desafio é agir com rapidez, garantir resultados e manter o equilíbrio produtivo das lavouras.
Com esse objetivo, a Syngenta Biologicals lança Neture®, um inseticida microbiológico de última geração, desenvolvido para ampliar os horizontes do manejo biológico e oferecer resultados consistentes em diferentes culturas.

Inovação que combina eficiência e conveniência
Neture® combina duas cepas complementares de bactérias do gênero Pseudomonas (Pseudomonas chlororaphis e Pseudomonas fluorescens) em uma formulação líquida estável que dispensa refrigeração e apresenta alta compatibilidade com defensivos químicos.
Essa combinação inovadora entrega ação rápida e residual prolongado, atuando de forma eficaz no controle de cigarrinha-do-milho, percevejo, mosca-branca e pisilídeo no citrus, pragas conhecidas pela alta capacidade de adaptação e resistência.
O modo de ação múltiplo de Neture® se destaca por liberar metabólitos com efeito imediato por contato e contaminação tarsal, interferir nos sistemas nervoso e digestivo dos insetos e ainda exercer efeito repelente, reduzindo novas infestações. Além disso, o produto estimula o metabolismo das plantas, promovendo maior vigor e tolerância a estresses, o que o torna um aliado importante dentro dos programas de manejo integrado de pragas.

Aplicação simples e resultados consistentes
Prático e versátil, Neture® foi desenvolvido para se integrar facilmente à rotina de manejo no campo. A dose recomendada é de 0,8 L/ha, aplicada por pulverização foliar no início da infestação ou de forma preventiva, quando as condições ambientais favorecem o desenvolvimento das pragas.
Sua compatibilidade com inseticidas e fungicidas químicos permite que o produtor combine tecnologias, ampliando o espectro de controle e prolongando o efeito residual. Essa integração reduz a pressão de resistência e garante lavouras protegidas por mais tempo.
Diferenciais que impulsionam o campo
Neture® se diferencia pela combinação entre desempenho técnico, praticidade e sustentabilidade. Sua formulação oferece ação imediata após a aplicação e mantém um efeito prolongado sobre as principais pragas sugadoras.
O produto atua tanto em ninfas quanto em adultos, proporcionando uma proteção abrangente e eficaz. Além disso, age como bioativador, estimulando o crescimento das plantas e melhorando o aproveitamento dos nutrientes, o que resulta em lavouras mais vigorosas e produtivas.
Outro destaque é a conveniência: Neture® não requer refrigeração e tem excelente estabilidade, facilitando o armazenamento e reduzindo custos operacionais. Com alta compatibilidade química, o inseticida biológico pode ser integrado facilmente ao manejo já existente, sem a necessidade de mudanças estruturais.

Mais produtividade e sustentabilidade em uma única aplicação
Em campo, os resultados de Neture® são visíveis. As lavouras mostram maior equilíbrio fisiológico, resistência a estresses e ganhos de produtividade, dependendo das condições da cultura e do manejo adotado.
Por unir eficiência, praticidade e sustentabilidade, Neture® representa uma nova era no controle biológico de pragas. O produto oferece ao agricultor segurança no manejo e retorno agronômico consistente, sem comprometer o equilíbrio ambiental.

A força da biotecnologia Syngenta Biologicals
Com o lançamento de Neture®, a Syngenta Biologicals reforça seu compromisso em desenvolver soluções baseadas em ciência, tecnologia e simplicidade de uso. Segundo,Rafael Pereira Oliveira gerente de Marketing e Produtos Biológicos da Syngenta, “Neture® traduz a nova geração de inseticidas biológicos: uma solução eficaz, fácil de aplicar e capaz de transformar o manejo de pragas sugadoras em ganhos reais de produtividade.”
Cada produto é pensado para responder às necessidades reais do produtor, garantindo eficiência agronômica e sustentabilidade.
Leia também no Mais Agro
– Ambimobilidade e o ineditismo no controle de pragas do algodão
– Vinhaça localizada associada a inseticida: os benefícios na cana
– Da recuperação do solo à prosperidade
NETURE™. Máximo controle com a máxima praticidade.
Syngenta Biologicals®. Inovação movida pela natureza.





Deixe um comentário